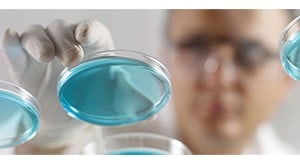
Alfa Aesar - Life Science

Alfa Aesar products available through Fisher Scientific
Alfa Aesar products available through Fisher Scientific
Alfa Aesar, now part of Thermo Fisher Scientific, offers leading manufacturer and supplier services for research chemicals, metals and materials in a wide span of applications.
For more than 50 years, scientists have relied on us to supply high purity raw materials for a variety of research and development applications. Today we offer over 46,000 products in stock, in sizes from gram-scale catalogue items to semi-bulk and bulk production quantities.
With custom manufacturing capabilities to supply many specialized items, we are a one-stop source for research chemicals, metals and materials.
Explore your favourite Alfa Aesar Products Now:

Organics and Organometallics
Through our own manufacturing facilities and key manufacturing partnerships, Alfa Aesar provides a broad range of organometallic and organic compounds. Our broad experience in manufacturing, sourcing and handling a wide range of chemical materials enables us to respond quickly and efficiently to your needs.
Inorganics
Known worldwide as a leading supplier of high purity inorganic compounds with over 30 years of experience, Alfa Aesar delivers thousands of distinct materials to exacting standards for research, development and production applications. Our brands are recognized for purity and quality and are backed by technical and sales teams dedicated to providing the best service.
Alfa Aesar is a leading supplier of life science research tools. Our product line focuses on high quality reagents/biochemicals to support academic and biotech research. We manufacture and supply novel reagents for many life science research areas including but not limited to genomic & proteomic analysis, cell culture, molecular biology, and imaging.

You can count on Alfa Aesar for a broad range of high purity metals and materials, virtually all of which are available from stock for immediate shipment. Alfa Aesar supplies pure metals, alloys, and non-metallic elements in various purities and forms to meet most specifications.
In addition to pure elements and alloys, you will find here a variety of forms of carbon, ceramics for high temperature applications, evaporation materials, products for brazing, optics, crystals, and even a selection of fuel cell grade catalysts. Lastly, we offer selected laboratory equipment, such as magnetic susceptability balances, hydrogen purifies, and more.

Precious Metal Compounds and Homogeneous Catalysts
Alfa Aesar offers a full range of precious metal salts and solutions manufactured to stringent specifications. Homogeneous catalysis provides an excellent choice where highly specific reactions are desired including chiral transformations. Our homogeneous catalysts can be used in a wide range of chemical transformations.

Alfa Aesar is known worldwide for a variety of high purity products used in analytical chemistry. Recognized for purity and quality, our products and brands are backed by technical and sales teams dedicated to providing you the best service possible.
In this section you will find our Specpure® analytical standards, manufactured for unsurpassed performance in accuracy, purity, and quality. Also listed are hundreds of other products, including MS standards, HPLC solvents, analytical graphite products, pH test strips and solutions, indicators, acids and bases, Labware (Base metal, PTFE, carbon, ceramic), and a selection of infrared spectroscopy products.
Alfa Aesar Capabilities Brochure
Working together, building partnerships. Focused on developing customer relationships
- Alfa Aesar Capabilities Brochure (4.7 MB)
High Purity Metals And Materials
Alfa Aesar™ offers a broad range of high purity metals and materials, virtually all of which are available from stock for immediate shipment.
- High Purity Metals And Materials (549.4 KB)
Substituted Trifluoromethyl Organics
New reagents and catalysts for substituting organics with trifluoromethyl groups
- Substituted Trifluoromethyl Organics (327.4 KB)
Practical Fluorination Chemistry
Current Trends in Practical Fluorination Chemistry
- Practical Fluorination Chemistry (414.5 KB)
Freight Charges applicable for all Alfa Aesar products.
Please check with our customer services the exact rates applicable for your country.
